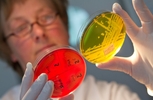

Сайт належить Товариству з обмеженою відповідальністю "Інформаційна Агенція Житомир Інфо". Код ЄДРПОУ 33732896
Адміністрація сайту може не розділяти думку автора і не несе відповідальності за авторські матеріали.
При повному чи частковому використанні матеріалів Житомир.info обов’язкове гіперпосилання
(для інтернет-ресурсів), або письмова згода редакції (для друкованих видань)
Матеріали, позначені значками: "Р" - розміщують на правах реклами або партнерства
© 2025 Zhitomir.INFO Всі права захищені. Розроблено агентством